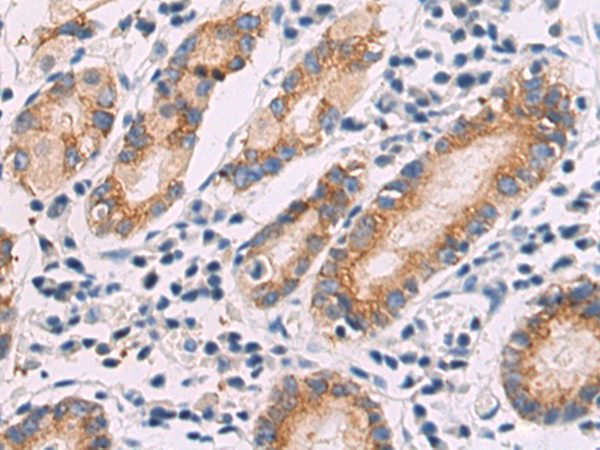
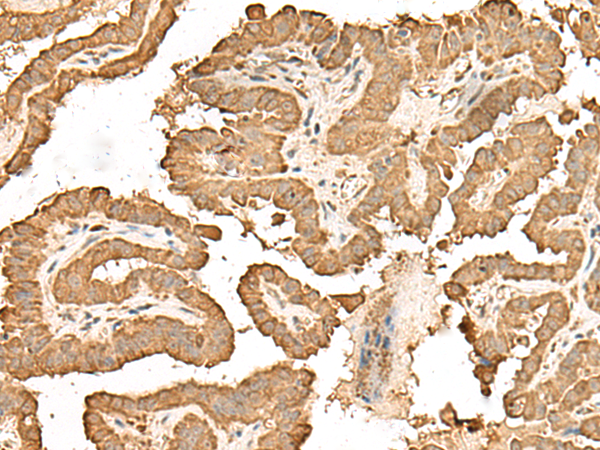

-
分类: 科研抗体货号: P02688别名: Erv46; CGI-54; C2orf47; PRO0989; C20orf47; NY-BR-84; SDBCAG84; dJ477O4.2应用: WB,IHC反应种属: Human, Mouse
-
分类: 科研抗体货号: P02733别名: SIS; SSV; IBGC5; PDGF2; c-sis; PDGF-2应用: WB,IHC反应种属: Human, Mouse, Rat
-
分类: 科研抗体货号: P02779别名: ACSMW; AVYV493应用: WB,IHC反应种属: Human, Mouse, Rat
-
分类: 科研抗体货号: P02731别名: COVID-19; 2019-nCoV; SARS-CoV-2; Nucleocapsid protein; Nucleoprotein; 新型冠状病毒; 新冠病毒应用: WB反应种属: SARS-CoV-2/2019-nCoV、Virus
-
分类: 科研抗体货号: P02769别名: BTF4; RAP74; TF2F1; TFIIF应用: WB,IHC反应种属: Human, Mouse, Rat
-
分类: 科研抗体货号: P02729别名: COVID-19; 2019-nCoV; SARS-CoV-2; spike glycoprotein; 新型冠状病毒; 新冠病毒应用: WB反应种属: SARS-CoV-2/2019-nCoV、Virus
-
分类: 科研抗体货号: P02768别名:应用: WB反应种属: Human, Mouse, Rat
-
分类: 科研抗体货号: P02725别名: ETF; TEF4; TEF-4; TEAD-2应用: IHC反应种属: Human, Mouse
-
分类: 科研抗体货号: P02762别名: IgA1应用: IHC反应种属: Human
-
分类: 科研抗体货号: P02815别名: S25应用: IHC反应种属: Human, Mouse, Rat

鄂公网安备42018502007531号
鄂公网安备42018502007531号

